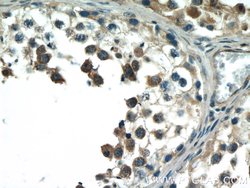
BCMO1 Rabbit anti-Human, Mouse, Polyclonal, Proteintech 150 &mu;L; Unconjugated:Antibodies,

missing translation for 'onlineSavingsMsg'
Learn More
Learn More
BCMO1 Rabbit anti-Human, Mouse, Polyclonal, Proteintech
Rabbit Polyclonal Antibody
Brand: Proteintech 23308-1-AP-150UL
This item is not returnable.
View return policy
Description
Vitamin A metabolism is important for vital processes such as vision, embryonic development, cell differentiation, and membrane and skin protection. The protein encoded by this gene is a key enzyme in beta-carotene metabolism to vitamin A. It catalyzes the oxidative cleavage of beta, beta-carotene into two retinal molecules.Specifications
| BCMO1 | |
| Polyclonal | |
| Unconjugated | |
| BCO1 | |
| BCMO1, Beta carotene dioxygenase 1 | |
| Rabbit | |
| Antigen Affinity Chromatography | |
| RUO | |
| 53630, 63857 | |
| -20°C | |
| Liquid |
| Immunohistochemistry (Paraffin), Western Blot | |
| 0.36 mg/mL | |
| PBS with 50% glycerol and 0.02% sodium azide; pH 7.3 | |
| Q9HAY6, Q9JJS6 | |
| BCO1 | |
| BCMO1 Fusion Protein Ag19732 | |
| 150 μL | |
| Primary | |
| Human, Mouse | |
| Antibody | |
| IgG |
Product Content Correction
Your input is important to us. Please complete this form to provide feedback related to the content on this product.
Product Title
Spot an opportunity for improvement?Share a Content Correction